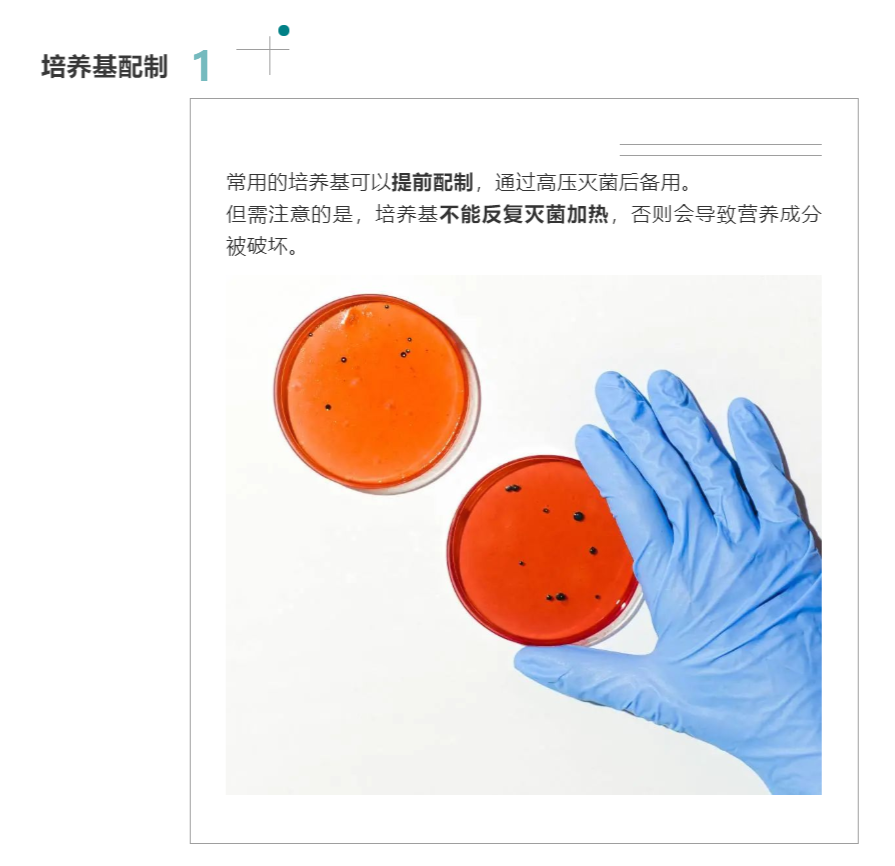
111.png

有獎調研丨如何提高微生物實驗的效率?
發布日期:2022-03-09 15:04
微生物實驗總是耗時耗力,該如何提高實驗效率是眾多實驗員長期煩惱的事情。小睿發現了一些小技巧,一起來看看吧!
文末還有福利,中獎率百分之百,千萬別錯過!





微生物實驗總是耗時耗力,該如何提高實驗效率是眾多實驗員長期煩惱的事情。小睿發現了一些小技巧,一起來看看吧!
文末還有福利,中獎率百分之百,千萬別錯過!